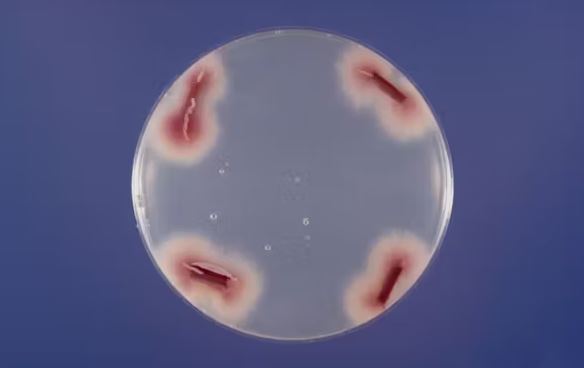
تلاش برای نجات موز در حال انقراض

تلاش برای نجات موز در حال انقراض
به گزارش خبرنگار گروه علم و فناوری خبرگزاری برنا؛ FWB از Gros Michel توسط fusarium oxysporum race 1 ، یک پاتوژن قارچی که موز را تحت تاثیر قرار می دهد ، ایجاد شده است. این عفونت قارچی با اشغال سیستم عروقی گیاه را از بین می برد و مانع حمل و نقل آب و مواد معدنی می شود.
زیست شناسان گیاهی انواع Cavendish مقاوم به فوزاریوم را برای جایگزینی Gros Michel توسعه دادند. با این حال ، در چند دهه گذشته ، ظهور مجدد FWB ناشی از یک سویه متفاوت از همان قارچ به نام نژاد گرمسیری 4 یا TR4 ، یک بار دیگر تولید جهانی موز را تهدید می کند.
چگونه fusarium oxysporum توانایی غلبه بر مقاومت و آلوده کردن بسیاری از گیاهان مختلف را به دست آورد ؟
ژنوم دو بخشی f. oxysporum
oxysporum می تواند باعث بیماری های پوسیدگی و پوسیدگی ریشه در بیش از 120 گونه گیاهی شود. سویه های خاصی نیز می توانند افراد را آلوده کنند.
در سال ۲۰۱۰ ، آزمایشگاه کشف کرد که هر ژنوم f. oxysporum را می توان به دو بخش تقسیم کرد: ژنوم هسته ای که در میان تمام سویه هایی که برای عملکردهای ضروری خانه داری کدگذاری می کنند ، و ژنوم لوازم جانبی متفاوت از سویه به سویه که برای عملکردهای تخصصی مانند توانایی آلوده کردن یک میزبان گیاه خاص کدگذاری می کند.
هر گونه گیاه دارای یک پاسخ ایمنی پیچیده به دفاع در برابر تهاجم میکروبی است. بنابراین برای ایجاد عفونت ، هر سویه f. oxysporum از ژنوم جانبی خود برای سرکوب سیستم دفاعی منحصر به فرد گیاه استفاده می کند. این تقسیم بندی کاربردی به f. oxysporum اجازه می دهد تا دامنه میزبان خود را به شدت افزایش دهد.
در تحقیقات تازه منتشر شده ، محققان در چین و آفریقای جنوبی دریافتند که سویه TR4 که موز کاوندیش را می کشد ، منشأ تکاملی متفاوتی دارد و توالی های مختلفی در ژنوم جانبی آن در مقایسه با سویه ای که موز گراس میشل را کشت ، دارد.
با نگاه کردن به رابط کاربری که در آن سویه TR4 با میزبان موز کاوندیش خود مبارزه می کند ، ما دریافتیم که برخی از ژن های جانبی فعال آن اکسید نیتریک را آزاد می کنند ، گازی که برای موز کاوندیش مضر است.
این انفجار ناگهانی گازهای سمی با خلع سلاح سیستم دفاعی گیاه ، عفونت را تسهیل می کند. در عین حال ، قارچ با افزایش تولید مواد شیمیایی که اکسید نیتریک را سم زدایی می کنند ، از خود محافظت می کند.
افزایش تنوع موز
در ردیابی گسترش جهانی این نسخه جدید فوساریوم اکسیسپوروم ، محققان متوجه شدند که یک علت اصلی برای احیای اخیر این عفونت قارچی ، تسلط صنعت بین المللی موز توسط یک کلان موز است.
رشد انواع مختلف موز می تواند کشاورزی را پایدارتر کند و فشار بیماری را بر روی یک محصول کاهش دهد. کشاورزان و محققان می توانند با شناسایی یا توسعه انواع موز که در برابر TR4 مقاوم یا مقاوم هستند ، پژمردگی فوزاریوم موز را کنترل کنند.
یافته های نشان می دهد که راه دیگری برای محافظت از موز کاوندیش طراحی پاک کننده های اکسید نیتریک موثر برای کاهش فشار سمی انفجار گاز است.
تصور اینکه مصرف کننده ای که به سادگی از خوردن موز لذت می برد چگونه می تواند در مبارزه با این بیماری که محصولات موز را ویران می کند ، شرکت کند ، دشوار است. با این حال ، مصرف کنندگان بازار را تعیین می کنند و کشاورزان مجبور به رشد آنچه بازار می خواهد هستند.
شما می توانید به افزایش تنوع موز در سوپرمارکت خود کمک کنید با عمدا امتحان کردن یکی یا چند تا از صدها نوع موز موجود دیگر وقتی که آنها در آنجا ظاهر می شوند. همچنین می توانید انواع محلی میوه ها و محصولات کشاورزی دیگر را برای کمک به حفظ تنوع گیاهان و حمایت از کشاورزان محلی خریداری کنید.
همکاری بین دانشمندان ، کشاورزان ، صنعت و مصرف کنندگان در سراسر جهان می تواند به جلوگیری از کمبود موز و سایر محصولات در آینده کمک کند.
انتهای پیام/




